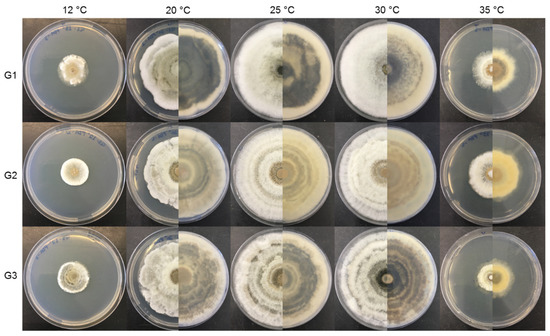

Abstract
Sweet chestnut (Castanea sativa Miller) is a nutritious food with high social and economic impacts in Portugal. The fungus Gnomoniopsis smithogilvyi (syn. Gnomoniopsis castaneae) is the causal agent of chestnut brown rot, and is currently considered one of the major threats to the chestnut production chain worldwide. Considering the lack of knowledge on both the disease and the causal agent in Portugal, studies were conducted in an attempt to develop the necessary control strategies towards the mitigation of the disease in a timely way. Isolates of G. smithogilvyi were selected from three varieties of chestnut from the northeast of Portugal, and were characterized at the morphological, ecophysiological and molecular levels. Tests of pathogenicity and virulence were also developed. Gnomoniopsis smithogilvyi was confirmed as the causal agent of brown rot disease in Portuguese chestnut varieties, which showed high susceptibility. The fungus showed high adaptability to chestnut substrates. The Portuguese isolates of G. smithogilvyi are morphologically and genetically similar to those from other countries, even though some physiological variability was observed among them.
1. Introduction
The fruits of the European chestnut (Castanea sativa Miller) play an important role in human nutrition, especially for populations in the Mediterranean basin [1]. The chestnut also represents a relevant economic contribution to many European countries [2], such as Portugal, especially in the northeastern region of Trás-os-Montes, which is responsible for 88% of the Portuguese chestnut area and 82% of the production [3]. The region holds three chestnut protected denominations of origin (PDOs)—Terra Fria, Soutos da Lapa and Padrela. Among the 13 registered varieties in the region, three are of high productive and commercial significance—Longal, Judia and Martaínha [4,5]. Longal is highly distributed in the region and is considered the best variety for transformation, while Judia and Martaínha are preferably consumed fresh due to their higher caliber. Due to the nutritional characteristics of the sweet chestnut, combined with its high water content, the fruits are a substrate conducive to the development of fungi that cause post-harvest rot, affecting quality and, consequently, the commercial value of the chestnut.
Over the last decades, a sharp increase in the incidence of chestnuts presenting rot, with symptoms atypical to those of diseases that normally affect the fruits, has been observed by producers in Australia and New Zealand, and in some regions of Europe, such as Italy and France [6,7,8,9,10]. In 2012, the causal agent of this new chestnut fruit rot was attributed to the fungus Gnomoniopsis smithogilvyi L.A. Shuttlew, E.C.Y. Liew & D.I. Guest (2012) (syn. Gnomoniopsis castaneae G. Tamietti 2012), described as a new phytopathogenic fungal species.
Gnomoniopsis smithogilvyi infects the nut kernel, developing into browning and necrosis of the endosperm and embryo [11], and resulting in what is called brown chestnut rot. The disease is mainly expressed after harvest and it is cryptic, as healthy-looking nuts on the surface are rotten internally. The infection is initially asymptomatic, so it is assumed that the fungus colonizes chestnut tissues as an endophyte, becoming pathogenic as the nuts ripen. At early infection stages, the slightly moldy or parasitized nuts are not easily differentiated from the good ones, and infection is detected only when they are processed or consumed. Floral infection by ascospores or conidia is considered to be the main route of infection, but other infection paths, such as inoculum entrance via shell defects, are not ruled out [12]. The fungus shows the capacity to persist saprophytically in the burs and other residues on the ground, which represent the main reservoir for the formation of perithecia and subsequent release of infectious spores [9,11,13]. There is still a lack of knowledge on the potential of airborne inoculum and its dispersal pattern in time and space, as well as on the role of the climate in the infection patterns [14].
Currently, G. smithogilvyi is considered the main emerging fungus causing rot in chestnuts over a vast geographic area covering three continents. In Italy, Visentin et al. [9] reported an increase in the frequency of the isolation of this fungus in chestnuts from 29.2 ± 22.7% in 2008 to 74.6 ± 9.4% in 2011. Maresi et al. [15] also reported a 49% incidence of brown rot caused by this pathogen. In Australia and Switzerland, in the years 2013 and 2015, an incidence of chestnut rot of 72 and 91% was reported, respectively [10,16]. In Portugal, farmers started reporting an “unknown” rot in 2018, for which special evidence was gathered in 2019, and it is currently considered to be responsible for up to 80 or 90% of chestnut production losses in some regions of the country (non-published data). This fungus has now been isolated, identified, characterized and reported in chestnuts from the United Kingdom [17], United States of America [18], Chile [19], Spain [20], Ireland [21] and Turkey [22]. In Portugal, the first reports of the isolation of G. smithogilvyi from pre-harvest chestnuts were in 2017 [23] and in 2021 [24], and in post-harvest chestnuts in 2019 [25]. Although no extensive surveys about the incidence of G. smithogilvyi have been carried out in Portugal, Rodrigues et al. [25] reported a 6.4% incidence in stored chestnuts that had already been visually selected, with rejected chestnuts showing as much as 40% infection.
A small number studies reported the presence of G. smithogilvyi in Portugal and established its relation to the chestnut brown disease, but did not characterize the fungus in terms of virulence, ecophysiology and genetic relatedness to other isolates from different geographic origins. Due to the lack of knowledge and studies on Portuguese isolates from this phytopathogenic agent and its behavior in Portuguese chestnut varieties, the objectives of this work were to comprehensively morphologically, ecophysiologically and molecularly characterize three selected isolates of G. smithogilvy from three Portuguese varieties of C. sativa, Judia, Longal and Martaínha, to determine their pathogenicity and virulence in chestnuts of these varieties and to evaluate the natural infection of the fruits of these varieties by this fungus.
2. Materials and Methods
2.1. Biological Material
The assays were carried out in the production year of 2019/2020, using three varieties of sweet chestnut (C. sativa)—Judia, Longal and Martaínha. These varieties were selected based on their economic importance and generalized geographic distribution in the region of Trás-os-Montes [4,5] and their apparent susceptibility to fungal growth as reported by Rodrigues et al. [25]. The chestnut samples were collected from a local industry in paper bags, transported to the Mycology Laboratory of CIMO (Centro de Investigação de Montanha), Instituto Politécnico de Bragança, Portugal, and preserved at 4 °C until analysis (max. 48 h).
The isolates of G. smithogilvyi used in the present study were previously collected from local chestnuts, cultivar Longal (isolates G1 and G2) and Judia (isolate G3), from the production year 2018/2019, and identified molecularly as described in Rodrigues et al. [25]. Isolates G1, G2 and G3 were deposited in the culture collection “Micoteca of Universidade do Minho (MUM)”, Braga, Portugal, with the codes MUM 20.139, MUM 20.140 and MUM 20.141, respectively. All isolates were grown on potato dextrose agar (PDA, BioLife, Milan, Italy) for 5 days at 25 °C before analysis.
2.2. Tests of Pathogenicity and Virulence of G. smithogilvyi Isolates
2.2.1. Preparation of Chestnuts
Chestnuts from the three varieties were carefully inspected for defects, such as discoloration, broken pericarp (shell), irregular tenderness, signs of pest infestation and fungal infection. Only apparently healthy nuts were selected. Nuts were washed with running tap water, surface-disinfected with 10% commercial bleach (0.5% sodium hypochloride) for 10 min, rinsed twice with sterilized water and blot-dried in sterile paper towels in a laminar flow hood. After that, the nuts were submitted to UV light for 20 min.
2.2.2. Preparation of Spore Suspensions
For this assay, the isolates G1 and G2 were used from 7-day-old PDA cultures grown at 25 °C. Conidiomata were collected from the plate using a sterile loop and homogenized by vortexing in sterile water with 0.1% Tween 80. Spore concentrations were determined using a Neubauer counting chamber, and were adjusted to 2 × 107 spores/mL in sterile water with 0.1% Tween 80.
2.2.3. Inoculation and Incubation
For each binomium fungal isolate and chestnut variety, three different methods of inoculation were tested. In all methods, chestnuts were placed in 250 mL glass jars (three chestnuts each), and 20 µL of the spore suspension was used as inoculum. The inoculation methods were as follows: (i) intact chestnuts were superficially inoculated (on the pericarp) in three spots—near the hilum, near the embryo and in the center; (ii) chestnuts were perforated with a sterile needle in three spots, and inoculated on the whole; (iii) chestnuts were longitudinally cut in half with a sterile scalpel, and the two halves of the endosperm were inoculated. For each treatment and each variety, six non-inoculated chestnuts were used as the control. In total, 48 jars and 144 chestnuts were used. Chestnuts were incubated in the dark at 25 °C for 15 days.
2.2.4. Evaluation of Infection Rate in Chestnuts Inoculated with G. smithogilvyi
Chestnuts were longitudinally cut and the fungal infection rate was registered in terms of incidence, and the severity of infection rate was registered in terms of percentage of chestnut area with visible rot as proposed by Donis-González et al. [26]: Level 0 (L0): no visible rot; Level 1 (L1): 1–25% of the chestnut area with rot; Level 2 (L2): 26–50%, Level 3 (L3): 51–75% and Level 4 (L4): 76–100%. Incidence was registered as the percentage of infected chestnuts. The severity was then calculated from these infection levels using the McKinney index [27]. This index takes into account the intensity of the rot (severity), its frequency and the maximum possible value, according to the equation
where d is the category of rot intensity scored for chestnuts, f is the rot frequency, N is the total number of examined chestnuts (healthy and rotted) and D is the highest category of rot intensity that occurred.
2.2.5. Verification of Koch’s Postulates
The Koch’s postulates were verified in the inoculated chestnuts that showed the development of brown rot. The rot-causing agent was re-isolated from each infected fruit in PDA Petri dishes and was incubated for 7 days at 25 °C in the dark, after which it was morphologically identified and compared with the original cultures.
2.3. Natural Incidence of G. smithogilvyi in Chestnuts
This assay was performed to evaluate the endophytic incidence of the fungus. For this, 36 glass flasks and 108 chestnuts (36 of each variety) were used. Chestnuts were selected and surface-disinfected as previously described, and were divided into four sets (for each variety). They were longitudinally cut and incubated for 7 days, and the intact chestnuts were incubated for 7, 14 and 21 days. All treatment groups were incubated at 25 °C, and carried out in triplicate (total of 9 chestnuts per treatment for each chestnut variety). After the incubation period, the intact chestnuts were longitudinally cut and the fungal infection rate was registered in terms of percentage of chestnut area with visible rot [26], as previously described.
2.4. Morphological and Cultural Characterization of the Isolates
2.4.1. Biological Material and Culture Media
In this assay, the isolates G1, G2 and G3 were used. Growth parameters were evaluated in three media: potato dextrose agar (PDA, Biolife, Italy), malt extract agar (MEA, Himedia, Mumbai, India) and chestnut medium (MC). PDA and MEA were used as standard media for comparison purposes with previously reported data [9,11]. The media were prepared following the manufacturers’ instructions. MC was used as a model medium to mimic the chemical and nutritional conditions of chestnuts to better understand the isolates’ ecophysiology, in particular, the adaptability to chestnut as a substrate. For the preparation of MC, fresh and healthy chestnuts (balanced mix of the three varieties Judia, Longal and Martaínha) were cooked for 15 min in a microwave, shelled and blended using a kitchen blender in the proportion of 200 g per 1 L of distilled water. Agar was added at 2%, and the medium was autoclaved for 121 °C for 15 min.
2.4.2. Inoculation and Growth Parameters
Spore suspensions of each isolate were prepared at 3 × 107 spores/mL as previously described. Petri dishes with a 9 cm diameter containing 20 mL of each medium were central point-inoculated with 20 µL of each spore suspension (in triplicate), and were incubated at 5, 12, 20, 25, 30 and 35 °C for 9 days in the dark.
Fungal growth was measured in two directions daily for nine days or until the colony achieved the maximum diameter (8.5 cm). From these data, the following parameters were calculated: (i) lag phase (λ, in days), corresponding to the number of days from inoculation until mycelial growth was visible and (ii) mean growth rate (κ, day−1), calculated from the slope of the regression line in the exponential phase from the colony diameter plotted against incubation time. Spores were counted for each culture medium 9 days after inoculation, but only for the 25 °C incubation. For this, spores were collected from the entire plate by flooding the medium with 10 mL of 0.9% NaCl with 0.1% Tween 80, and were counted with a Neubauer hematocytometer.
2.4.3. Measurement of Conidia and Conidiomata
At least 100 conidia and 50 conidiomata of 7-day-old cultures of each culture medium were measured transversally and longitudinally using a microscope and a stereomicroscope, respectively, both coupled to Leica Application Suite V4 (LAS V4.12) software. Measures are expressed as (minimum)–mean–(maximum) (length × width).
2.5. Molecular Characterization of the Isolates
Genomic DNA of the isolates was extracted following the SDS protocol described by Rodrigues et al. [28]. A portion of the internal transcribed spacer (ITS) of the ribosomal RNA locus (600 bp amplicons) and of the gene encoding the translation elongation factor 1α (TEF-1α; 1000 bp amplicons) were amplified through PCR using the primer pairs ITS1 (5′-CTTGGTCATTTAGAGGAAGTAA-3′)/ITS4 (5′-TCCTCCGCTTATTGATATGC-3′) [29], and EF1-728F (5′-CATCGAGAAGTTCGAGAAGG-3′)/EF1-1567R (5′-ACHGTRCCRATACCACCRATCTT-3′) [30,31]. The reactions occurred in a final volume of 25 μL using the following protocol: 94 °C, 3 min; 94 °C, 30 s; 55 °C, 30 s; 72 °C, 2 min (35 cycles); 72 °C, 10 min. The PCR products were purified using the GF-1 purification kit (Vivantis, Selangor Darul Ehsan, Malaysia) following the manufacturer’s instructions, and were then sequenced in both directions by STAB VIDA (Caparica, Portugal), using ABI 3730xl equipment (Applied Biosystems, Waltham, MA, USA). The sequences were processed manually, and a consensus sequence was created using the BioEdit v7.0.9 and Sequencher® Version 4.9 (Demo version) programs. The consensus sequences were compared with the ones in the GenBank NCBI (National Centre for Biotechnology Information) database (http://www.ncbi.nlm.nih.gov/, accessed on 15 October 2020) using the BLASTn (nucleotide Basic Local Alignment Search Tool) algorithm. The sequences were deposited in GenBank with the accession numbers MW165483—MW165485 (ITS) and MW170363—MW170365 (TEF1-α gene).
Alignments were generated using ClustalX [32]. Phylogenetic trees were constructed using MEGA11 [33], using the neighbor-joining method [34] and the Jukes–Cantor parameters method [35] with 1000 bootstrap replicates. The evolutionary distances were computed using the maximum composite likelihood method [36]. Sequences of G. smithogilvyi isolates from different geographic regions obtained in previous studies were retrieved from GenBank and used for comparison.
2.6. Statistical Analysis
Since both the severity and incidence raw and transformed data failed the normality criteria, a non-parametric analysis was applied using the Kruskal–Wallis test followed by the post hoc Mann–Whitney test. The level of significance was established for p < 0.05. Tests were run with the IBM SPSS® Statistics v. 22 software.
In the ecophysiology assays, the logarithm (Ln) of the diametral growth was used to determine the mean growth rate (κ) and the R2 value was used to determine the experimental data fitting the model. All the growth rate values were compared to determine significant differences between conditions using GraphPad v. 8.0. Since the data failed the normality premise, a non-parametric analysis was applied using the Kruskal–Wallis test followed by multiple comparisons to evaluate the influence of culture media, isolates and temperature on the growth parameters lag phase, mean growth rate and sporulation.
3. Results
3.1. Natural Incidence of G. smithogilvyi in Chestnuts
The results for the natural incidence and severity (as given by the McKinney index) of G. smithogilvyi in chestnuts are presented in Table 1. Given the high variability of incidence, no significant differences were observed between varieties (p = 0.721) or incubation conditions (p = 0.920).

Table 1.
Natural incidence (%) and severity (McKinney index) of brown rot caused by G. smithogilvyi in chestnut varieties Longal, Judia and Martaínha (n = 9 ± SD).
3.2. Tests of Pathogenicity and Virulence of G. smithogilvyi Isolates
Overall, there was no significant difference in either incidence or severity between chestnut varieties (p = 0.596) and fungal strains (p = 0.774) in inoculated chestnuts (Table 2; Figure 1). Differences were found between treatments for both parameters (p < 0.0001). After the Mann–Whitney tests, no significant difference was detected in rot incidence and severity between cut and perforated fruits (p = 1.000), where the fungus had direct contact with the endosperm. In contrast, in intact fruits, the fungus caused significantly lower disease incidence and severity, resulting in significant differences between the treatments intact/cut and intact/perforated (p = 0.000). In the exposed cotyledons (cut chestnuts), the fruits were fully infected (100% of infected area) by the fungus, which was always re-isolated, following the Koch’s postulates.

Table 2.
Incidence (%) and severity (McKinney index) of brown rot caused by G. smithogilvyi in chestnut varieties Longal, Judia and Martaínha artificially infected with two strains of the fungus, G1 and G2 (n = 6). Different letters mean significant differences between methods of inoculation), after Kruskal–Wallis non-parametric analysis followed by the post hoc Mann–Whitney test.

Figure 1.
Chestnuts inoculated with G. smithogilvyi and observed after 15 days of incubation at 25 °C. Cut chestnuts inoculated with strains G1 (A) and G2 (B), and not inoculated (C). Perforated chestnuts inoculated with strains G1 (D) and G2 (E), and not inoculated (F). Intact chestnuts inoculated with strains G1 (G) and G2 (H), and not inoculated (I).
3.3. Morphology and Ecophysiology of G. smithogilvyi
Under standard conditions, G. smithogilvyi produced a relatively dense and woolly mycelium, with a beige color, diffuse to regular margins, with concentric rings of yellowish conidiomata on the obverse and dark on the reverse of the colony (Figure 2). In CM, the morphology of the fungus differed from that in PDA by being denser and more aerial, with fewer but bigger conidiomata showing an irregular distribution (no evident ring distribution). Conidiomata were abundant, globose to subglobose, viscous, with colors varying from cream to light orange, mostly yellow to light orange (Figure 3).

Figure 2.
G. smithogilvyi colonies after 7 days of incubation at 25 °C. Top: isolate G1: (A) obverse in PDA, (B) reverse in PDA, (C) obverse in CM. Middle: isolate G2: (D) obverse in PDA, (E) reverse in PDA, (F) obverse in CM; Bottom: isolate G3: (G) obverse in PDA, (H) reverse in PDA, (I) obverse in CM.

Figure 3.
Morphological details of G. smithogilvyi isolates G1 (top line), G2 (middle line) and G3 (bottom line) in PDA, after 7 days of incubation at 25 °C. (A,D,G) Colony center, rich in conidiomata distributed in concentric rings. (B,E,H) Details of conidiomata. (C,F,I) Conidia.
The conidia from G. smithogilvyi showed variable shapes and sizes, mostly straight or slightly curved, cylindrical or ellipsoidal (Figure 3C,F,I). In general, the average conidia size for the three isolates did not show major differences between culture media. In contrast, the size of the conidiomata showed significant differences between both culture media and isolates (p < 0.05), despite the high size diversity observed (Table 3). On the other hand, the substrate significantly influenced the size of the conidiomata, which were significantly bigger in CM (average of the three strains 435 µm) than in the other tested media (209 µm in PDA; and 67 µm in MEA).

Table 3.
Conidiomata size (n = 50) and conidia length and width (n = 100) of G. smithogilvyi isolates G1, G2 and G3 in potato dextrose agar (PDA), malt extract agar (MEA) and chestnut medium (CM). Min–Mean–Max (SD: standard deviation).
The three isolates of G. smithogilvyi presented intraspecific differences in colony morphology and growth (Figure 4 and Figure 5) when grown in the media PDA and CM at different temperatures (12, 20, 25, 30 and 35 °C).
Figure 4.
Growth of the three isolates of G. smithogilvyi (G1, G2 and G3) at five different temperatures (12, 20, 25, 30 and 35 °C) in PDA, after 7 days of incubation (obverse/reverse).

Figure 5.
Growth of the three isolates of G. smithogilvyi (G1, G2 and G3) at five different temperatures (12, 20, 25, 30 and 35 °C) in CM, after 7 days of incubation.
Figure 6 shows the growth rates of the three isolates in each of the three culture media for the temperature range 5 to 35 °C (MEA was not tested at 35 °C). Even though no significant differences were observed for each isolate between the temperatures 20, 25 and 30 °C (p > 0.05), optimal growth occurred between 25 and 30 °C with growth rates of 3.5 to 6 mm/day. The growth rate was similar between PDA and MEA (p = 1.000), but significantly higher in CM (p < 0.05) for all isolates.

Figure 6.
Growth rate of G. smithogilvyi (isolates G1, G2 and G3) in potato dextrose agar (PDA), and chestnut medium (CM), at temperatures from 5 to 35 °C, and malt extract agar (MEA) at temperatures from 5 to 30 °C.
The results for lag phase and conidia production are presented in Figure 7. The lag phase was not significantly different between the isolates for the same temperature, considering each culture medium (p > 0.05). Within the 20 to 30 °C range, the fungus started to grow immediately after inoculation (lag phase = 0 days), while at 5, 12 and 35 °C, the lag phase was significantly longer (p = 0.000). It is noteworthy that for these suboptimal temperatures, the lag phase was significantly lower in CM when compared with PDA and MEA.

Figure 7.
(a) Lag phase (in days) and (b) spore counts for G. smithogilvyi in potato dextrose agar (PDA), and chestnut medium (CM), at temperatures from 12 to 35 °C, and in malt extract agar (MEA) at temperatures from 12 to 30 °C.
In terms of conidia production, there was no significant difference between the culture media (p = 0.379), but temperature significantly influenced this parameter, ranging from 3.5 log10 spores/mL (MC, 12 °C) to 9 log10 spores/mL (MC, 30 °C). It is noted that the isolates produced the lowest amount of spores in CM for all temperatures except at 30 °C.
3.4. Molecular Characterization
The molecular analysis of the G. smithogilvyi isolates was performed on the basis of the ITS region and the TEF1-α gene (Figure 8). In this analysis, sequences of G. smithogilvyi isolates with different geographical origins were retrieved from GenBank (19 ITS and 13 TEF1-α sequences). Gnomoniopsis paraclavulata Sogonov was used as the tree root for both molecular markers. The phylogenetic analysis of the G. smithogilvyi isolates showed a very close relation between the isolates from this study and those retrieved from GenBank, including the type of strain. This is in agreement with other studies [15,16], where no differences were detected between isolates with worldwide geographic distribution.

Figure 8.
Phylogenetic tree for G. smithogilvyi isolates. (a) ITS region for 23 sequences, in a total of 513 nucleotide positions; (b) TEF1-α partial gene for 17 sequences, in a total of 1005 nucleotide positions. The optimal tree is shown, as inferred using the neighbor-joining method [34]. The tree is drawn to scale, with branch lengths (above the branches) in the same units as those of the evolutionary distances used to infer the phylogenetic tree. The evolutionary distances, computed using the maximum composite likelihood method [36], are in the units of the number of base substitutions per site. All ambiguous positions were removed for each sequence pair (pairwise deletion option).
4. Discussion
In recent years, many studies have been conducted on the fungal pathogen G. smithogilvyi, mostly from countries where the chestnut is a significant commercial product [37,38,39,40]. In Portugal, Coelho and Gouveia [23] described G. smithogilvyi as the causal agent of brown chestnut rot for the first time, and it has been isolated from Portuguese chestnuts at frequencies ranging from 9.3% to 15.3% [23,25,41], but no studies have been previously reported on the morphology and ecophysiology of the isolates from Portugal and their comparison to the ones isolated from other geographical areas.
In the present study, G. smithogilvyi was isolated from asymptomatic chestnuts from three C. sativa Portuguese varieties—Judia, Longal and Martaínha confirming its endophytic behavior, as also reported by others from various geographic origins [9,12,15,16]. No significant differences were observed for incidence between the three varieties (Table 1). The Koch postulates confirmed G. smithogilvyi to be the causal agent of chestnut brown rot. Pathogenicity and virulence assays revealed that all of the tested G. smithogilvyi isolates were capable of colonizing the chestnut tissue, showing high virulence and causing intense symptoms of brown rot in all chestnut varieties (Figure 1). These assays also revealed the role of the outer shell in controlling the development of the disease, mostly in the case where infection occurs from external propagules. Even though the fungus shows endophytic behavior, infections may also occur after harvest if the shell is ruptured. These assays demonstrate the importance of chestnut management practices at both pre- and post-harvest stages of chestnut production, as suggested by Silva-Campos et al. [39].
Our study provided detailed data on the main morphological and ecophysiological characteristics of three isolates of G. smithogilvyi. The colony showed a yellowish tone and the presence of numerous yellow to orange conidiomata (Figure 2 and Figure 3), typical of the genus Gnomoniopsis [42]. The Portuguese isolates were similar to those from Australia, Italy, New Zealand and India [9,11,13], in terms of colony aspect as well as conidia and conidiomata size and morphology when grown in PDA. In contrast, in MEA, the conidiomata of the isolates were significantly smaller than those from Australia [11]. Additionally, the average growth rate at 25 °C in MEA was higher (approximately 4 mm/day) than that reported by Visentin et al. [9] (0.8 to 1.0 mm/day). This difference may be related to the method of calculation, since in our study, the growth rate considered only the logarithmic phase.
From a molecular perspective, our isolates showed a very high degree of genetic similarity (>99%) for the ITS region to the isolates from Australia, Chile, Slovenia, Spain, the USA, France, Italy, New Zealand, the United Kingdom and Switzerland [9,17,18,19,43,44]; (Figure 8). The TEF1-α sequence showed a higher diversity among isolates, with the Portuguese ones closer to those from Chile and Australia. Silva-Campos et al. [40] developed and validated a multiplex PCR assay for G. smithogilvyi detection, and observed a very low level of genetic divergence between Australian isolates and those from other geographic origins.
In a study by Lione et al. [14], the authors reported that the production of conidia and other growth parameters by G. smithogilvyi are dependent on various factors such as the biological features of the isolate and the climatic and environmental conditions. In fact, in the present study, the ecophysiological studies were conducted in three different culture media, PDA, MEA and CM. While PDA and MEA were the media used for fungal characterization by others [9,11,42], a chestnut-based medium mimicking the substrate of interest had not been tested previously. By comparing growth parameters in CM with those in PDA and MEA, it was clear that G. smithogilvyi shows an optimal adaptation to chestnut, namely lower lag phase, higher growth rate and higher mycelial growth (lower conidia production). It is also interesting to note that growing in MC at 30 °C stimulates the production of conidia, which might reflect an adaptation to stressful temperatures. This effect may have a negative impact on the virulence of the fungus, which could potentially increase under the conditions of climate change already in place.
Author Contributions
Conceptualization, P.R.; methodology, P.R. and G.P.; validation, P.R. and A.S.; formal analysis, G.P., P.R. and A.S.; investigation, P.R. and G.P.; resources, P.R.; data curation, P.R.; writing—original draft preparation, G.P., A.S. and P.R.; writing—review and editing, P.R., R.D.-G. and A.S.; supervision, P.R. and R.D.-G.; funding acquisition, P.R., A.S. and J.G.-L. All authors have read and agreed to the published version of the manuscript. This research work is part of the master’s thesis of Guilherme Possamai.
Funding
This work was funded by the project “ValorCast—Valorização da castanha e otimização da sua comercialização”, ref. PDR2020-101-032030, funded by the Fundo Europeu Agrícola de De-senvolvimento Rural (FEADER) and Portuguese Government, under the scope of Ação 1.1 «Grupos Operacionais», Medida 1. «Inovação», PDR 2020—Programa de Desenvolvimento Rural do Con-tinente, as well as the Foundation for Science and Technology (FCT, Portugal) and FEDER under Pro-grame PT2020 for financial support to CIMO (UID/AGR/00690/2020), SusTEC (LA/P/0007/2020), CITAB (UID/AGR/04033/2020), and Inov4Agro (LA/P/0126/2020).
Institutional Review Board Statement
Not applicable.
Informed Consent Statement
Not applicable.
Data Availability Statement
Not applicable.
Conflicts of Interest
The authors declare no conflict of interest.
References
- Vasconcelos, M.C.B.M.; Bennett, R.N.; Rosa, E.A.S.; Ferreira-Cardoso, J.V. Composition of European chestnut (Castanea sativa Mill.) and association with health effects: Fresh and processed products. J. Sci. Food Agric. 2010, 90, 1578–1589. [Google Scholar] [CrossRef] [PubMed]
- FAO. Food and Agriculture Organization of the United Nations (FAO), Production of Chestnut by Countries, Statistics Division. 2022. Available online: https://www.fao.org/faostat/en/#home (accessed on 15 September 2022).
- INE. Estatísticas Agrícolas 2020; Instituto Nacional de Estatística: Lisbon, Portugal, 2021. [Google Scholar]
- Matos, A. O Sistema de Comercialização de Castanha da Terra Fria Transmontana e Sua Cadeia de Valor. Master’s Dissertation, Universidade de Trás-os-Montes e Alto Douro, Vila Real, Portugal, 2003. Available online: http://hdl.handle.net/10198/930 (accessed on 13 December 2022).
- Gomes-Laranjo, J.; Ferreira-Cardoso, J.; Portela, E.; Abreu, C.G. Castanheiros; Universidade de Trás-os-Montes e Alto Douro: Vila Real, Portugal, 2007; ISBN 978-972-669-844-9. [Google Scholar]
- Smith, H.C.; Ogilvy, D. Nut rot in chestnuts. Austral. Nutgrow. 2008, 2, 10–15. [Google Scholar]
- Smith, H.C.; Agri, M. The life cycle, pathology, and taxonomy of two different nut rot fungi in chestnut. Austral. Nutgrow. 2008, 22, 11–15. [Google Scholar]
- Gentile, S.; Valentino, D.; Visentin, I.; Tamietti, G. Discula pascoe infections of sweet chestnut fruits in North-West Italy. Austral. Nutgrow. 2009, 23, 23–25. [Google Scholar]
- Visentin, I.; Gentile, S.; Valentino, D.; Gonthier, P.; Tamietti, G.; Cardinale, F. Gnomoniopsis castanea sp. nov. (Gnomoniaceae, Diaporthales) as a causal agent of nut rot in sweet chestnut. J. Plant Pathol. 2012, 94, 411–419. [Google Scholar]
- Shuttleworth, L.A.; Liew, E.C.Y.; Guest, D.I. Survey of the incidence of chestnut rot in south-eastern Australia. Australas. Plant Pathol. 2013, 42, 63–72. [Google Scholar] [CrossRef]
- Shuttleworth, L.A.; Guest, D.I.; Liew, E.C.Y. Fungal Planet Description Sheet 107: Gnomoniopsis smithogilvyi. Persoonia 2012, 28, 142–143. [Google Scholar] [CrossRef]
- Shuttleworth, L.A.; Guest, D.I. The infection process of chestnut rot, an important disease caused by Gnomoniopsis smithogilvyi (Gnomoniaceae, Diaporthales) in Oceania and Europe. Australas. Plant Pathol. 2017, 46, 397–405. [Google Scholar] [CrossRef]
- Dar, M.A.; Rai, M.K. Gnomoniopsis smithogilvyi a canker causing pathogen on Castanea sativa: First report. Mycosphere 2015, 6, 327–336. [Google Scholar] [CrossRef]
- Lione, G.; Giordano, L.; Sillo, F.; Brescia, F.; Gonthier, P. Temporal and spatial propagule deposition patterns of the emerging fungal pathogen of chestnut Gnomoniopsis castaneae in orchards of north-western Italy. Plant Pathol. 2021, 70, 2016–2033. [Google Scholar] [CrossRef]
- Maresi, G.; Oliveira Longa, C.M.; Turchetti, T. Brown rot on nuts of Castanea sativa Mill: An emerging disease and its causal agent. iForest 2013, 6, 294–301. [Google Scholar] [CrossRef]
- Dennert, F.G.; Broggini, G.A.L.; Gessler, C.; Storari, M. Gnomoniopsis castanea is the main agent of chestnut nut rot in Switzerland. Phytopathol. Mediterr. 2015, 54, 41–53. [Google Scholar]
- Lewis, A.; Gorton, C.; Rees, H.; Webber, J.; Perez-Sierra, A. First report of Gnomoniopsis smithogilvyi causing lesions and cankers of sweet chestnut in the United Kingdom. New Dis. Rep. 2017, 35, 20. [Google Scholar] [CrossRef]
- Sakalidis, M.L.; Fulbright, D.W.; Kolp, M.; Medina Mora, C. First report of Gnomoniopsis smithogilvyi causing chestnut brown rot on chestnut fruit in Michigan. Plant Dis. 2019, 103, 2134. [Google Scholar] [CrossRef]
- Cisterna-Oyarce, V.; Carrasco-Fernández, J.; Castro, J.F.; Santelices, C.; Muñoz-Reyes, V.; Millas, P.; Buddie, A.G.; France, F. Gnomoniopsis smithogilvyi: Identification, characterization and incidence of the main pathogen causing brown rot in postharvest sweet chestnut fruits (Castanea sativa) in Chile. Australas. Plant Dis. Notes 2022, 7, 2. [Google Scholar] [CrossRef]
- Aguín, O.; Rial, C.; Piñón, P.; Sainz, M.J.; Mansilla, J.P.; Salinero, C. First report of Gnomoniopsis smithogilvyi causing chestnut brown rot on nuts and burrs of sweet chestnut in Spain. Plant Dis. 2023, 107, 218. [Google Scholar] [CrossRef]
- O’Loinsigh, B.; McAuley, D.; Bréchon, A.L.; Lopez Vernaza, M.; Ryan, C.; Destefanis, M.L.; O’Hanlon, R. First report of the fungus Gnomoniopsis smithogilvyi causing cankers on sweet chestnut (Castanea sativa) in Ireland. New Dis. Rep. 2022, 45, e12072. [Google Scholar] [CrossRef]
- Çakar, D.; Şimşek, S.A. First report of Gnomoniopsis smithogilvyi causing nut rot on Castanea sativa in Turkey. New Dis. Rep. 2022, 46, e12105. [Google Scholar] [CrossRef]
- Coelho, V.; Gouveia, E. Fungos associados com as podridões da castanha. In I Congresso Luso-Brasileiro de Horticultura; Associação Portuguesa de Horticultura: Lisbon, Portugal, 2017; p. 162. [Google Scholar]
- Coelho, V.; Gouveia, E. Gnomoniopsis smithogilvyi, the causal agent of chestnut brown rot reported from Portugal. New Dis. Rep. 2021, 43, e12007. [Google Scholar] [CrossRef]
- Rodrigues, P.; Driss, J.O.; Gomes-Laranjo, J.; Sampaio, A. impact of cultivar, processing and storage on the mycobiota of european chestnut fruits. Agriculture 2022, 12, 1930. [Google Scholar] [CrossRef]
- Donis-González, I.R.; Guyer, D.E.; Fulbright, D.W. Quantification and identification of microorganisms found on shell and kernel of fresh edible chestnuts in Michigan. J. Sci. Food Agric. 2016, 96, 4514–4522. [Google Scholar] [CrossRef] [PubMed]
- McKinney, H.H. Influence of soil temperature and moisture on infection of wheat seedlings by Helminthosporium sativum. J. Agric. Res. 1923, 26, 195–218. [Google Scholar]
- Rodrigues, P.; Venâncio, A.; Lima, N. Toxic reagents and expensive equipment: Are they really necessary for the extraction of good quality fungal DNA? Lett. Appl. Microbiol. 2018, 66, 32–37. [Google Scholar] [CrossRef]
- White, T.J.; Bruns, T.; Lee, S.; Taylor, J. Amplification and Direct Sequencing of Fungal Ribosomal RNA Genes for Phylogenetics. In PCR Protocols; Elsevier: Amsterdam, The Netherlands, 1990; pp. 315–322. [Google Scholar] [CrossRef]
- Carbone, I.; Kohn, L.M. A method for designing primer sets for speciation studies in filamentous ascomycetes. Mycologia 1999, 91, 553–556. [Google Scholar] [CrossRef]
- Rehner, S.A.; Buckley, E. A Beauveria phylogeny inferred from nuclear ITS and EF1-α sequences: Evidence for cryptic diversification and links to Cordyceps teleomorphs. Mycologia 2005, 97, 84–98. [Google Scholar] [CrossRef] [PubMed]
- Thompson, J.D.; Gibson, T.J.; Plewniak, F.; Jeanmougin, F.; Higgins, D.G. The CLUSTAL_X windows interface: Flexible strategies for multiple sequence alignment aided by quality analysis tools. Nucleic Acids Res. 1997, 25, 4876–4882. [Google Scholar] [CrossRef]
- Tamura, K.; Stecher, G.; Kumar, S. MEGA11: Molecular Evolutionary Genetics Analysis version 11. Mol. Biol. Evol. 2021, 38, 3022–3027. [Google Scholar] [CrossRef]
- Saitou, N.; Nei, M. The neighbor-joining method: A new method for reconstructing phylogenetic trees. Mol. Biol. Evol. 1987, 4, 406–425. [Google Scholar]
- Jukes, T.H.; Cantor, C.R. Evolution of protein molecules. In Mammalian Protein Metabolism; Academic Press: New York, NY, USA, 1969; pp. 21–132. [Google Scholar] [CrossRef]
- Tamura, K.; Nei, M.; Kumar, S. Prospects for inferring very large phylogenies by using the neighbor-joining method. PNAS 2004, 101, 11030–11035. [Google Scholar] [CrossRef] [PubMed]
- Turco, S.; Bastianelli, G.; Morales-Rodrìguez, C.; Vannini, A.; Mazzaglia, A. development of a TaqMan qPCR assay for the detection and quantification of Gnomoniopsis castaneae in chestnut tissues. Forest Pathol. 2021, 51, e12701. [Google Scholar] [CrossRef]
- Bastianelli, G.; Morales-Rodríguez, C.; Caccia, R.; Turco, S.; Rossini, L.; Mazzaglia, A.; Thomidis, T.; Vannini, A. Use of phosphonate salts to control chestnut ‘brown rot’ by Gnomoniopsis castaneae in fruit orchards of Castanea sativa. Agronomy 2022, 12, 2434. [Google Scholar] [CrossRef]
- Silva-Campos, M.; Islam, M.T.; Cahill, D.M. Fungicide control of Gnomoniopsis smithogilvyi, causal agent of chestnut rot in Australia. Australas. Plant Pathol. 2022, 51, 483–494. [Google Scholar] [CrossRef]
- Silva-Campos, M.; Nadiminti, P.; Cahill, D. Rapid and accurate detection of Gnomoniopsis smithogilvyi the causal agent of chestnut rot, through an internally controlled multiplex PCR assay. Pathogens 2022, 11, 907. [Google Scholar] [CrossRef]
- Cuamba, M.U. Importância dos fatores bióticos (pragas e doenças) em pré-colheita na qualidade e conservação da castanha. Master’s Dissertation, Instituto Politécnico de Bragança, Bragança, Portugal, 2020. Available online: http://hdl.handle.net/10198/21803 (accessed on 15 December 2022).
- Sogonov, M.V.; Castlebury, L.A.; Rossman, A.Y.; Mejía, L.C.; White, J.F. Leaf-inhabiting genera of the Gnomoniaceae, Diaporthales. Stud. Mycol. 2008, 62, 1–77. [Google Scholar] [CrossRef] [PubMed]
- Shuttleworth, L.A.; Walker, D.M.; Guest, D.I. The chestnut pathogen Gnomoniopsis smithogilvyi (Gnomoniaceae, Diaporthales) and its synonyms. Mycotaxon 2015, 130, 929–940. [Google Scholar] [CrossRef]
- Trapiello, E.; Feito, I.; González, A.J. First report of Gnomoniopsis castaneae causing canker on hybrid plants of Castanea sativa × C. crenata in Spain. Plant Dis. 2018, 102, 1040. [Google Scholar] [CrossRef]
Disclaimer/Publisher’s Note: The statements, opinions and data contained in all publications are solely those of the individual author(s) and contributor(s) and not of MDPI and/or the editor(s). MDPI and/or the editor(s) disclaim responsibility for any injury to people or property resulting from any ideas, methods, instructions or products referred to in the content. |
© 2023 by the authors. Licensee MDPI, Basel, Switzerland. This article is an open access article distributed under the terms and conditions of the Creative Commons Attribution (CC BY) license (https://creativecommons.org/licenses/by/4.0/).